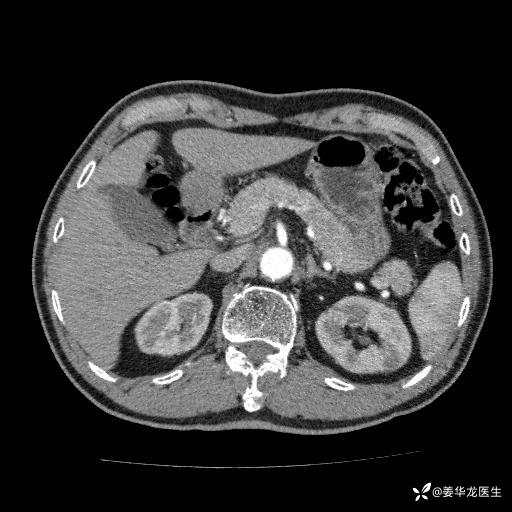
img
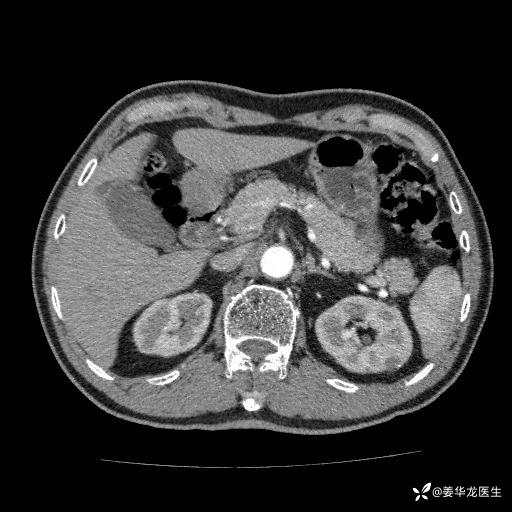
img
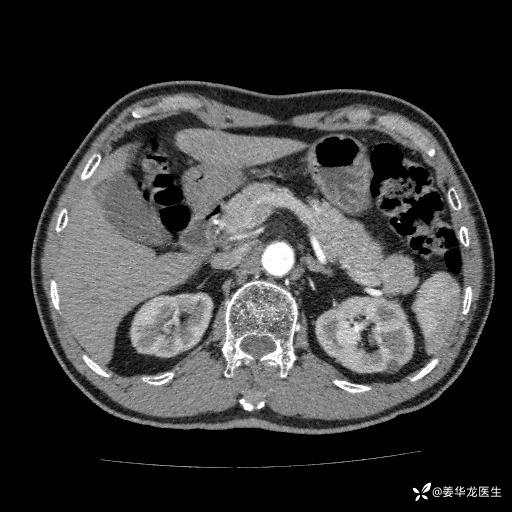
img
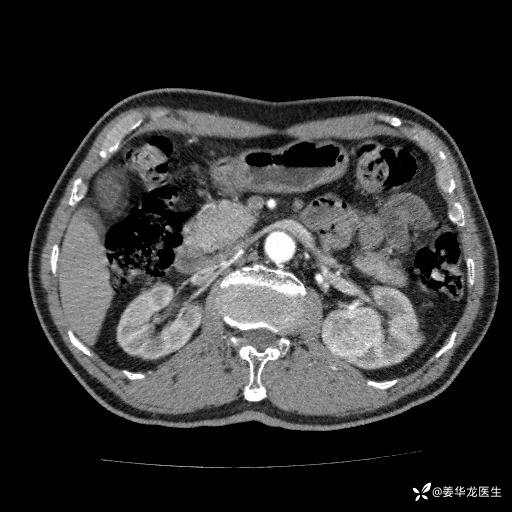
img
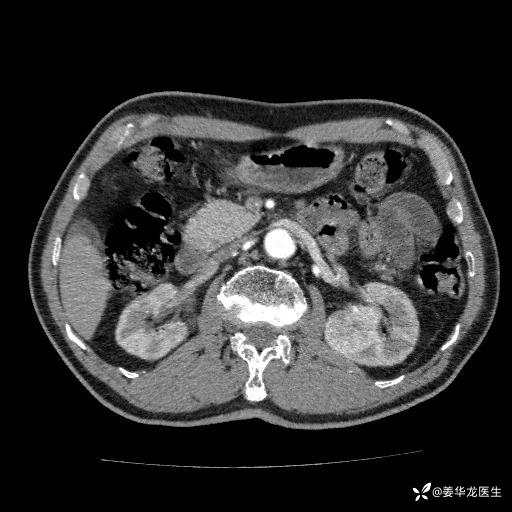
img
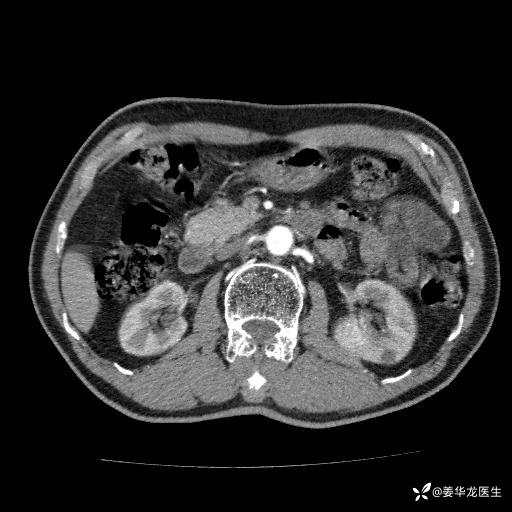
img

左肾中心型肾门部肿瘤39mm×34mm×36mm,右肾GFR25ml/min,部分切还是全切?
患者75岁老年男性,体重50kg,无高血压、肾病、糖尿病等基础病,检查发现左肾中心型肾门部肿瘤,右肾GFR只有25ml,无肉眼血尿,无镜下血尿。入院验血常规检查均正常,包括肾功能,肌酐102.7umol/L.
一、如何制定手术方案:
1.机器人辅助左肾部分切除术?
2.开放手术左肾部分切除术?
3.左肾根治疗切除术+透析
二、左肾肿瘤与左肾集合系、左肾动静脉关系密切,左肾部分切除术可行吗?成功率有多大?成功部分切后,肾功能还有多少?
三、患者无任何基础病,为什么右肾GFR只有25ml/min,反尔有肿瘤的左肾GFR达38.8ml/min?
四、左肾根治疗切除术后,透析的机率有多大?
五、有没有必要复查肾动态显像?